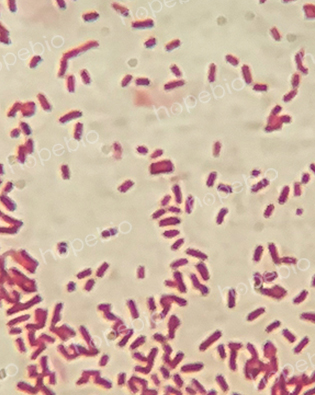
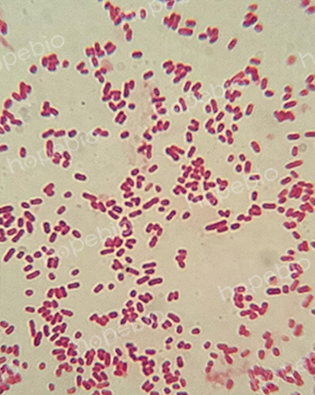
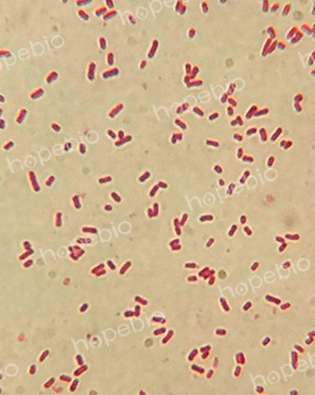
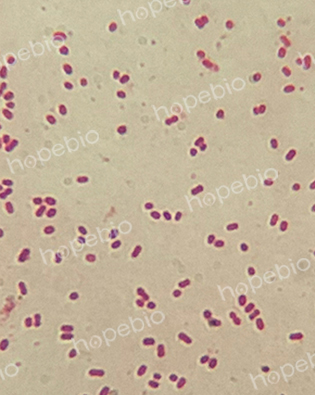
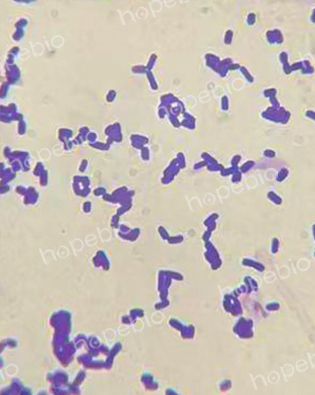
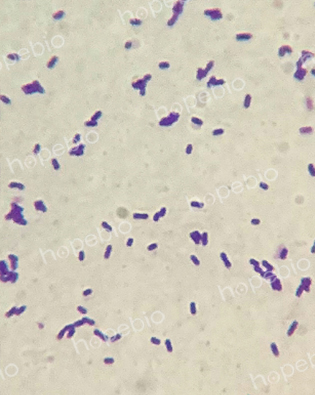

海博微信公众号
海博天猫旗舰店




一、革兰氏染色液成分及原理
革兰氏染色法是细菌学中广泛使用的一种鉴别染色法。未经染色之细菌,由于其与周围环境折光率差别甚小,故在显微镜下极难观察。染色后细菌与环境形成鲜明对比,可以清楚地观察到细菌的形态、排列及某些结构特征,而用以分类鉴定。
|
溶液 |
成分及配制方法 |
|
A液:结晶紫染色液 |
1g结晶紫溶于20mL 95%乙醇溶液中,与80mL 1%草酸铵溶液混合均匀 |
|
B液:碘液 |
1g碘与2g碘化钾混合溶解于少量蒸馏水中,补水至300mL |
|
C液:脱色液 |
95%乙醇溶液 |
|
D液:沙黄复染液 |
0.25g沙黄溶解于10mL 95%乙醇溶液中,加入90mL蒸馏水混合均匀 |
革兰氏阳性菌的细胞壁主要有90%的肽聚糖和10%的磷壁酸组成,几乎不含类脂质,厚度20-80nm。革兰氏阴性菌的细胞壁主要由肽聚糖、脂多糖构成,厚度约10-15nm。结晶紫初染和碘液媒染后,在菌体内形成了不溶于水的大分子复合物,在使用乙醇脱色时,革兰氏阳性菌由于其细胞壁较厚、肽聚糖网层次较多且交联致密,失水网孔缩小,把结晶紫与碘复合物牢牢留在壁内,使其仍呈紫色;革兰氏阴性菌其细胞壁薄、外膜层类脂含量高、肽聚糖层薄且交联度差,在遇脱色剂后,以类脂为主的外膜迅速溶解,薄而松散的肽聚糖网不能阻挡结晶紫与碘复合物的溶出,因此通过乙醇脱色后仍呈无色,再经沙黄等红色染料复染,就使革兰氏阴性菌呈红色。
二、操作步骤
1.涂片:在载玻片上滴少量纯化水,用接种环挑取少量菌苔涂开,自然干燥或微热干燥,再经火焰2-3次固定。
2.初染:加(结晶紫溶液)溶液A染1分钟,用清水冲去染液。
3.媒染:加(碘液)溶液B染1分钟,水洗。
4.脱色:加(95%乙醇)溶液C,不时摇动玻片约10-30秒,至无紫色脱落为止,水洗。
5.复染:加(沙黄复染液)溶液D,染1分钟,水洗。
6.观察:用滤纸吸水晾干后油镜镜检。阳性菌呈紫色、阴性菌呈红色。
三、注意事项
(1)涂片时挑取菌量不宜过多,涂片不宜过厚,否则可能导致染色不完全或脱色不完全。
(2)脱色是革兰氏染色操作中至关重要的一步,脱色时间要把握准确。脱色过度易导致革兰氏阳性菌染成红色,脱色不足易导致革兰氏阴性菌染成紫色。
(3)革兰氏染色宜选用细菌新鲜培养物。一些革兰氏阳性菌在培养时间过长后易出现老化现象,细胞壁发生改变,导致染色结果发生变化。
(4)并不是所有革兰氏阳性菌都会染成紫色,革兰氏阴性菌都会染成红色。一些细菌的细胞壁构成比较特殊或易发生改变,染色时会观察到相反的结果。
四、染色结果观察
(1)大肠埃希氏菌O157和普通大肠埃希氏菌、沙门氏菌为革兰氏阴菌,镜检形态为红色短杆菌。

大肠埃希氏菌O157:H7 ATCC35150
大肠埃希氏菌ATCC25922
鼠伤寒沙门氏菌ATCC14028
(2)志贺氏菌为革兰氏阴性短杆菌

福氏志贺氏菌ATCC12022
宋内志贺氏菌ATCC25931
痢疾志贺氏菌CMCC51252
(3)产气荚膜梭菌为革兰氏阳性梭杆菌,有时可见菌体内膨大不着色的芽孢结构;单增李斯特氏菌为革兰氏阳性无芽孢短杆菌;蜡样芽胞杆菌为革兰氏阳性芽孢长杆菌,常呈链状排列,菌体内或外有时可见不着色的椭圆形芽孢。
(4)金黄色葡萄球菌为革兰氏阳性球菌,常呈葡萄状堆积排列;副溶血性弧菌为革兰氏阴性杆菌,菌体略有弯曲呈弧状;唐菖蒲伯克霍尔德氏菌氏菌为革兰氏阴性杆菌。

产气荚膜梭菌ATCC13124
单增李斯特氏菌ATCC19114
蜡样芽胞杆菌ATCC11778
(5)普通变形杆菌、奇异变形杆菌、小肠结肠炎耶尔森氏菌为革兰氏阴性杆菌。



金黄色葡萄球菌ATCC25923
副溶血性弧菌ATCC17802
唐菖蒲伯克霍尔德氏菌CICC10574



普通变形杆菌CMCC49027
奇异变形杆菌CMCC49005
小肠结肠炎耶尔森氏菌CMCC52204
相关产品:
注:本文属海博生物原创,未经允许不得转载。
上一篇:细菌溶血试验原理及现象
下一篇:常见菌株的复苏与活化方法
